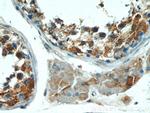
KLHL15 Antibody in Immunohistochemistry (Paraffin) (IHC (P))

Search
Proteintech
KLHL15 Polyclonal Antibody
{{$productOrderCtrl.translations['antibody.pdp.commerceCard.promotion.promotions']}}
{{$productOrderCtrl.translations['antibody.pdp.commerceCard.promotion.viewpromo']}}
{{$productOrderCtrl.translations['antibody.pdp.commerceCard.promotion.promocode']}}: {{promo.promoCode}} {{promo.promoTitle}} {{promo.promoDescription}}. {{$productOrderCtrl.translations['antibody.pdp.commerceCard.promotion.learnmore']}}
产品信息
25066-1-AP
种属反应
宿主/亚型
分类
类型
抗原
偶联物
形式
浓度
规格
纯化类型
保存液
内含物
保存条件
运输条件
产品详细信息
Immunogen sequence: MAGDVEGFC SSIHDTSVSA GFRALYEEGL LLDVTLVIED HQFQAHKALL ATQSDYFRIM FTADMRERDQ DKIHLKGLTA TGFSHVLQFM YYGTIELSMN TVHEILQAAM YVQLIEVVKF CCSFLLAKIC LENCAEIMRL LDDFGVNIEG VREKLDTFLL DNFVPLMSRP DFLSYLSFEK LMSYLDNDHL SRFPEIELYE AVQSWLRHDR RRWRHTDTII QNIRFCLMTP TSVFEKVKTS EFYRYSRQLR YEVDQALNYF QNVHQQPLLD MKSSRIRSAK PQTTVFRGMI GHSMVNSKIL LLKKPRVWWE LEGPQVPLRP DCLAIVNNFV FLLGGEELGP DGEFHASSKV F (1-350 aa encoded by BC109058)
靶标信息
KLHL15 is a member of a growing superfamily of kelch repeat-containing proteins. The kelch motif was discovered in the sequence of the Drosophila kelch ORF1 protein and forms a conserved beta-propeller tertiary structure. These kelch-like proteins have been implicated in embryogenesis and carcinogenesis through cytoskeleton organization. KLHL15 mRNA is widely expressed in many tissues and is thought to be involved in protein ubiquination and cytoskeleton organization.
仅用于科研。不用于诊断过程。未经明确授权不得转售。
生物信息学
蛋白别名: epididymis secretory protein Li 305; epididymis secretory sperm binding protein; kelch-like 15; Kelch-like protein 15; unnamed protein product
基因别名: HEL-S-305; KIAA1677; KLHL15; XLID103
UniProt ID: (Human) Q96M94
Entrez Gene ID: (Human) 80311